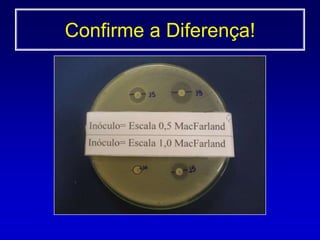
Método de crescimento0,5 McFarland 1a 2x108 UFC/mL
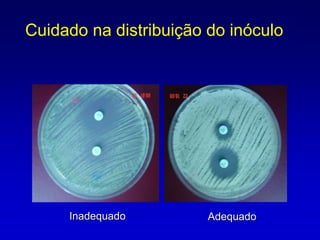
Ajustar a turbidez	0,5 McFarland1 a 2 x 108 UFC/mL  Estabilizar 15 min.TESTE DE SENSIBILIDADE AOS ANTIMICROBIANOSInóculo
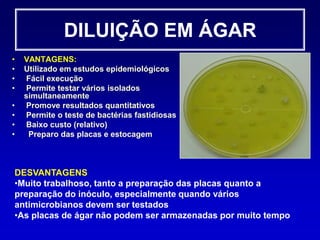
Data de validadeTESTE DE DIFUSÃO EM ÁGARInoculaçãoSuperfície do ágar não deve estar úmida

O documento discute os métodos para teste de sensibilidade a antimicrobianos (antibiograma), incluindo disco difusão em ágar, diluição em caldo, Etest e sistemas automatizados. Detalha etapas como preparo do inóculo bacteriano, escolha de meios de cultura, incubação, leitura e interpretação de resultados de acordo com padrões do CLSI. Aponta a importância desses testes para orientação terapêutica e monitoramento da resistência bacteriana.